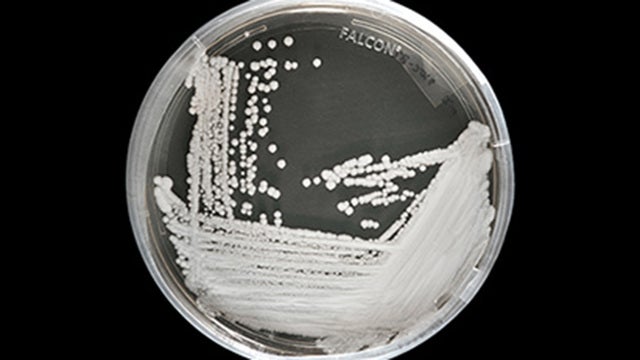
CDC: Deadly, drug-resistant fungus spreading through hospitals

Illinois Medicaid program to cover gender reassignment surgeries
The Medicaid program in Illinois will cover gender reassignment surgeries for members 21 and over who have been diagnosed with gender dysphoria, the state's health department announced.
The Medicaid program in Illinois will cover gender reassignment surgeries for members 21 and over who have been diagnosed with gender dysphoria, the state's health department announced.
Texas teacher goes viral for mental health check in board
A Texas teacher has been receiving a lot of online praise for a new method she has rolled out in her classroom to check in with students. It's called a 'mental health check in board,' and it allows students to communicate how they are feeling by using sticky notes.
A Texas teacher has been receiving a lot of online praise for a new method she has rolled out in her classroom to check in with students. It's called a 'mental health check in board,' and it allows students to communicate how they are feeling by using sticky notes.
Study: One alcoholic drink per day may increase stroke risk
More evidence that so-called moderate drinking may have more health risks than previously thought. A new study published in 'The Lancet' says even light to moderate drinking can increase your risk of a stroke.
More evidence that so-called moderate drinking may have more health risks than previously thought. A new study published in 'The Lancet' says even light to moderate drinking can increase your risk of a stroke.
Doctor suggests divorce to couple to help pay their child's medical bills: report
In order to pay their son’s extensive medical bills, a doctor reportedly suggested that a Tennessee couple get a divorce.
In order to pay their son’s extensive medical bills, a doctor reportedly suggested that a Tennessee couple get a divorce.
After 75 years, body of 82nd Airborne WWII soldier returns home
FORT BRAGG, N.C. -- Three quarters of a century after his death, the body of an 82nd Airborne soldier has come home.
FORT BRAGG, N.C. -- Three quarters of a century after his death, the body of an 82nd Airborne soldier has come home.
Officer retrieves stolen wallet of disabled Marine veteran
A police officer in Madison, Wisconsin recently went above and beyond the call of duty for a veteran who had his wallet stolen.
A police officer in Madison, Wisconsin recently went above and beyond the call of duty for a veteran who had his wallet stolen.
1 injured in Hapeville roof collapse
A worker was injured in a roof collapse in downtown Hapeville Tuesday morning.
A worker was injured in a roof collapse in downtown Hapeville Tuesday morning.
Georgia woman celebrates 100th birthday
A Georgia woman was all smiles Monday as she celebrated a huge milestone.
A Georgia woman was all smiles Monday as she celebrated a huge milestone.
I was there when 'The Hammer' made history
Forty-five years ago Monday Hank Aaron put Atlanta sports on the map when he took Al Downing deep in his second at-bat on a cool April night at Fulton County Stadium. Seven hundred and fifteen. Baseball's most famous number, unless you ask Joe DiMaggio fans who'll stick with sixty-two, or Cal Ripken faithful who will try to spit out two thousand, six-hundred thirty-two in converstation-...
Forty-five years ago Monday Hank Aaron put Atlanta sports on the map when he took Al Downing deep in his second at-bat on a cool April night at Fulton County Stadium. Seven hundred and fifteen. Baseball's most famous number, unless you ask Joe DiMaggio fans who'll stick with sixty-two, or Cal Ripken faithful who will try to spit out two thousand, six-hundred thirty-two in converstation-...
CDC: Deadly, drug-resistant fungus spreading through hospitals
The Centers for Disease Control (CDC) has issued a warning after healthcare facilities in several countries reported severe illness and death due to a drug-resistant fungus.
The Centers for Disease Control (CDC) has issued a warning after healthcare facilities in several countries reported severe illness and death due to a drug-resistant fungus.
Disneyland Star Wars park visitors will be given bathroom passes to use while waiting in line
Disneyland may be known as “The Happiest Place on Earth,” but there’s nothing happy about waiting in a long line — especially when that line is several hours long and you have to use the bathroom.
Disneyland may be known as “The Happiest Place on Earth,” but there’s nothing happy about waiting in a long line — especially when that line is several hours long and you have to use the bathroom.
Dog burned in Minnesota fire finds forever home with Indiana firefighter
A dog severely burned in a house fire in January found her forever home Saturday with a firefighter and his family.
A dog severely burned in a house fire in January found her forever home Saturday with a firefighter and his family.
George H.W. Bush honored by United States Postal Service with Forever stamp
The U.S. Postal Service has issued a stamp honoring George H.W. Bush.
The U.S. Postal Service has issued a stamp honoring George H.W. Bush.
California hospital lets children drive minicars into surgery to reduce stress
A hospital in California is helping ease their young patients' anxiety by letting them drive a minicar into the operating room.
A hospital in California is helping ease their young patients' anxiety by letting them drive a minicar into the operating room.
Illinois to ban those under 21 from buying tobacco
The state of Illinois will soon ban anyone under 21 from purchasing tobacco.
The state of Illinois will soon ban anyone under 21 from purchasing tobacco.
US measles tally hits 465, with most illnesses in kids
U.S. measles cases are continuing to jump, and most of the reported illnesses are in children.
U.S. measles cases are continuing to jump, and most of the reported illnesses are in children.
Nurses pay bond for dad who sped to hospital to save choking 1-year-old daughter
Several nurses bonded a father out of an Illinois jail after he was arrested for speeding while rushing his choking daughter to the hospital.
Several nurses bonded a father out of an Illinois jail after he was arrested for speeding while rushing his choking daughter to the hospital.
Surveillance camera catches man shoving chainsaw down his pants in order to steal it from store
Video taken by a surveillance camera from a hardware store in Fresno shows a man trying to steal a chainsaw, in a rather bizarre way.
Video taken by a surveillance camera from a hardware store in Fresno shows a man trying to steal a chainsaw, in a rather bizarre way.
Smoking pot vs. tobacco: What science says about lighting up
As more states make it legal to smoke marijuana, some government officials, researchers, and others worry about what that might mean for one of the country's biggest public health successes: curbing cigarette smoking.
As more states make it legal to smoke marijuana, some government officials, researchers, and others worry about what that might mean for one of the country's biggest public health successes: curbing cigarette smoking.
SeaWorld Orlando is officially a certified autism center
SeaWorld Orlando announced on Tuesday, which is World Autism Awareness Day, that they are now a certified autism center.
SeaWorld Orlando announced on Tuesday, which is World Autism Awareness Day, that they are now a certified autism center.